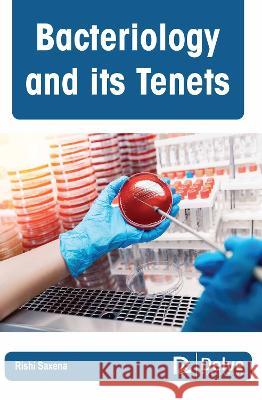
Bacteriology and Its Tenets Rishi Saxena 9781774695043 Delve Publishing

» książki » Science - Life Sciences - Bacteriology
 |
The Curious World of Bacteria
ISBN: 9781771648257 / Angielski / Twarda / 224 str. Termin realizacji zamówienia: ok. 5-8 dni roboczych. |
cena:
93,79 |
 |
Expanding Horizon of Cyanobacterial Biology
ISBN: 9780323912020 / Angielski / Miękka Termin realizacji zamówienia: ok. 5-8 dni roboczych. |
cena:
659,85 |
 |
Advances in Probiotics for Sustainable Food and Medicine
ISBN: 9789811567971 / Angielski / Miękka / 252 str. Termin realizacji zamówienia: ok. 5-8 dni roboczych. This book focuses on probiotics as sustainable foods and medicines, discussing issues such as screening and identification of probiotics, health claims, and advances in processing technologies, as well as food safety. Based on sound scientific research, the book is a unique reference resource for food scientists interested in development of probiotic based functional foods and their marketing. It will also appeal to those working in the area of regulations regarding the use of and health claims for fermented foods, both locally and globally. This book focuses on probiotics as sustainable foods and medicines, discussing issues such as screening and identification of probiotic... |
cena:
805,10 |
 |
Metagenomic Systems Biology: Integrative Analysis of the Microbiome
ISBN: 9789811585647 / Angielski / Miękka Termin realizacji zamówienia: ok. 5-8 dni roboczych. The book serves as an amalgamation of knowledge and principles used in the area of systems and synthetic biology, and targets inter-disciplinary research groups. The readers from diversified areas would be benefited by the valuable resources and information available in one book. Microbiome projects with efficient data handling can fuel progress in the area of microbial synthetic biology by providing a ready to use plug and play chassis. Advances in gene editing technology such as the use of tailor made synthetic transcription factors will further enhance the availability of... The book serves as an amalgamation of knowledge and principles used in the area of systems and synthetic biology, and targets inter-disciplinary re... |
cena:
644,07 |
 |
Recent Advances and Future Perspectives of Microbial Metabolites: Applications in Biomedicine
ISBN: 9780323901130 / Angielski / Miękka Termin realizacji zamówienia: ok. 5-8 dni roboczych. |
cena:
562,10 |
 |
Bacterial Survival in the Hostile Environment
ISBN: 9780323918060 / Angielski / Miękka Termin realizacji zamówienia: ok. 5-8 dni roboczych. |
cena:
659,85 |
 |
Cyanobacteria: Recent Advances in Taxonomy and Applications
ISBN: 9781839624896 / Angielski / Twarda / 106 str. Termin realizacji zamówienia: ok. 5-8 dni roboczych. |
cena:
611,78 |
 |
Bifidobacteria: Methods and Protocols
ISBN: 9781071612767 / Angielski / Miękka Termin realizacji zamówienia: ok. 5-8 dni roboczych. This volume provides current protocols that can be used in various experimental settings involving bifidobacteria. Chapters guide readers through experimental protocols on procedures to isolate and cultivate bifidobacteria, taxonomic identification of bifidobacterial isolates, sequencing and annotate genomes, physiologically characterize bifidobacteria, and methods on the genetic manipulation of bifidobacterial strains. Written in the highly successful Methods in Molecular Biology series format, chapters include introductions to their respective topics, lists of the necessary... This volume provides current protocols that can be used in various experimental settings involving bifidobacteria. Chapters guide readers through e... |
cena:
523,30 |
 |
Sulfate-Reducing Bacteria and Archaea
ISBN: 9783030967017 / Angielski / Twarda Termin realizacji zamówienia: ok. 5-8 dni roboczych. The abundance of sulfate-reducing bacteria and archaea (SRBA) is impressive and new isolates are being reported continuously. A few decades ago, only two genera of sulfate-reducing bacteria (SRB) had been identified. As of 2018, 92 genera containing more than 420 species of SRB have been isolated and characterized and there are several species of archaea. This book addresses the development of the research with SRBA and includes historical background of this field. Biochemical characterization of the enzymes, cytochromes and electron carriers involved with dissimilatory sulfate... The abundance of sulfate-reducing bacteria and archaea (SRBA) is impressive and new isolates are being reported continuously. A few decades a... |
cena:
603,81 |
 |
Circadian Rhythms in Bacteria and Microbiomes
ISBN: 9783030721602 / Angielski / Miękka Termin realizacji zamówienia: ok. 5-8 dni roboczych. This book addresses multiple aspects of biological clocks in prokaryotes. This book addresses multiple aspects of biological clocks in prokaryotes. |
cena:
805,10 |
 |
Cianobactérias e Cianotoxinas em Águas Continentais
ISBN: 9788576561026 / Portugalski / Miękka / 118 str. Termin realizacji zamówienia: ok. 5-8 dni roboczych. |
cena:
39,47 |
 |
Rhodopsin: Methods and Protocols
ISBN: 9781071623282 / Angielski / Twarda Termin realizacji zamówienia: ok. 5-8 dni roboczych. This volume provides readers with the latest information on the advances made in the field of rhodopsins. The chapters in this book cover topics such as new discoveries and developments; new ways to search for rhodopsins; methods to characterize the function and structure of rhodopsins on a molecular level; nano volume high throughput in meso crystallization, and fourth generation x-ray synchrotron sources. Written in the highly successful Methods in Molecular Biology series format, chapters include introductions to their respective topics, lists of the necessary materials and... This volume provides readers with the latest information on the advances made in the field of rhodopsins. The chapters in this book cover topics su... |
cena:
885,61 |
 |
Campylobacter
ISBN: 9781839689758 / Angielski / Twarda / 124 str. Termin realizacji zamówienia: ok. 5-8 dni roboczych. |
cena:
611,78 |
 |
Bacterial Physiology and Biochemistry
ISBN: 9780443187384 / Angielski / Miękka / 350 str. Termin realizacji zamówienia: ok. 5-8 dni roboczych. |
cena:
659,85 |
 |
The Readable Darwin: The Origin of Species Edited for Modern Readers
ISBN: 9780197575260 / Angielski / Twarda / 496 str. Termin realizacji zamówienia: ok. 5-8 dni roboczych. |
cena:
175,27 |
|
Bacteriology and Its Tenets
ISBN: 9781774695043 / Angielski / Twarda Termin realizacji zamówienia: ok. 5-8 dni roboczych. |
cena:
684,29 |
 |
Bioactive Microbial Metabolites: Scope and Challenges
ISBN: 9780443185687 / Angielski / Miękka Termin realizacji zamówienia: ok. 5-8 dni roboczych. Bioactive Microbial Metabolites: Scope and Challenges not only focuses on the identification, separation and purification of bioactive metabolites, the book also provides an understanding of the metabolic pathways for bioactive metabolites production that play an important role in modern healthcare as frontline treatments for many diseases. This is a valuable reference for research students, academicians and scientists in environmental microbiology and biotechnology, and for industry personnel related to microbiology/ biotechnology. The science discussed herein plays an important role in...
Bioactive Microbial Metabolites: Scope and Challenges not only focuses on the identification, separation and purification of bioactive metabolites, th...
|
cena:
659,85 |
 |
Actinobacteria: Ecology, Diversity, Classification and Extensive Applications
ISBN: 9789811633553 / Angielski / Miękka / 320 str. Termin realizacji zamówienia: ok. 5-8 dni roboczych. Through this book, the readers will learn about the different aspects ofActinobacteria-beginning with its ecology and occurrence, to the ways of its adaptation to harsh climates, and finally to its practical applications. The book also presents methods of identifying and characterizing this diverse group of bacteria through advanced techniques like MALDI-TOF, 16S rRNA analysis, etc. Different chapters describe the various biotechnological applications ofActinobacteria, including bioremediation, secondary metabolite production, and in producing antibiotics, anti-cancer therapeutics. It also...
Through this book, the readers will learn about the different aspects ofActinobacteria-beginning with its ecology and occurrence, to the ways of its a...
|
cena:
684,33 |
 |
Principles of Microbial Metabolism and Metabolic Ecology
ISBN: 9783031282171 / Angielski Termin realizacji zamówienia: ok. 5-8 dni roboczych. This textbook examines the fundamental principles of microbial metabolism and how a microbe's ecology is intrinsically interwoven with and a consequence of its metabolism. Further, it answers many questions frequently asked by students, such as: What are the mechanistic connections between simple phenotypic traits, ecological patterns and microbial metabolism and diversity? In the process, readers will be introduced to essential topics like metabolism and metabolic pathways, flux of energy and nutrients, genome size and fitness, competition, selection and drift.Moreover, the...
This textbook examines the fundamental principles of microbial metabolism and how a microbe's ecology is intrinsically interwoven with and a consequen...
|
cena:
402,53 |














